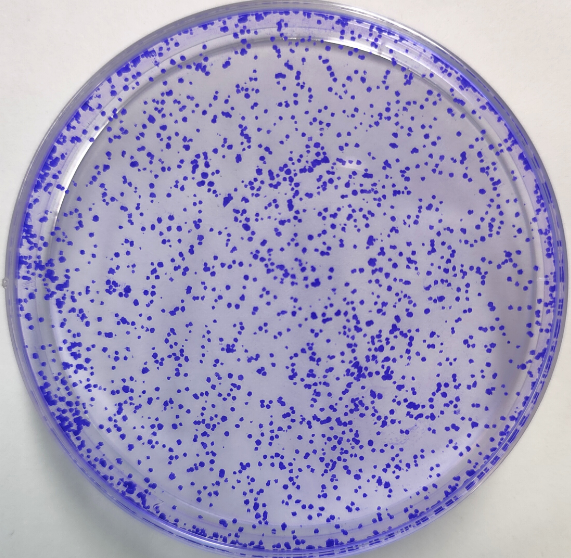

细胞克隆
- YZ-030
- 亚载生物
- 上海市
- 一个月内
- 按需定制
- 议价
- 2022-08-17 11:43:10
上海亚载生物科技有限公司
一键申请试用
咨询
加入意向单
联系方式
技术原理:
细胞接种存活率只表示接种细胞后贴壁的细胞数,但贴壁后的细胞不一定每个都能增殖和形成克隆。而形成克隆的细胞必为贴壁和有增殖活力的细胞。克隆形成率反映细胞群体依赖性和增殖能力两个重要性状。
实验方法
Step1:细胞培养
Step2:转染或药物处理
Step3:细胞收集
Step4:计数种板
Step5:染色检测
结果展示
实验周期及交付标准
1. 实验周期:2-3周,具体示工作量而定。
2. 交付标准:克隆形成图片、计数结果、柱状图、实验报告(实验步骤、试剂、仪器等)
为你推荐





